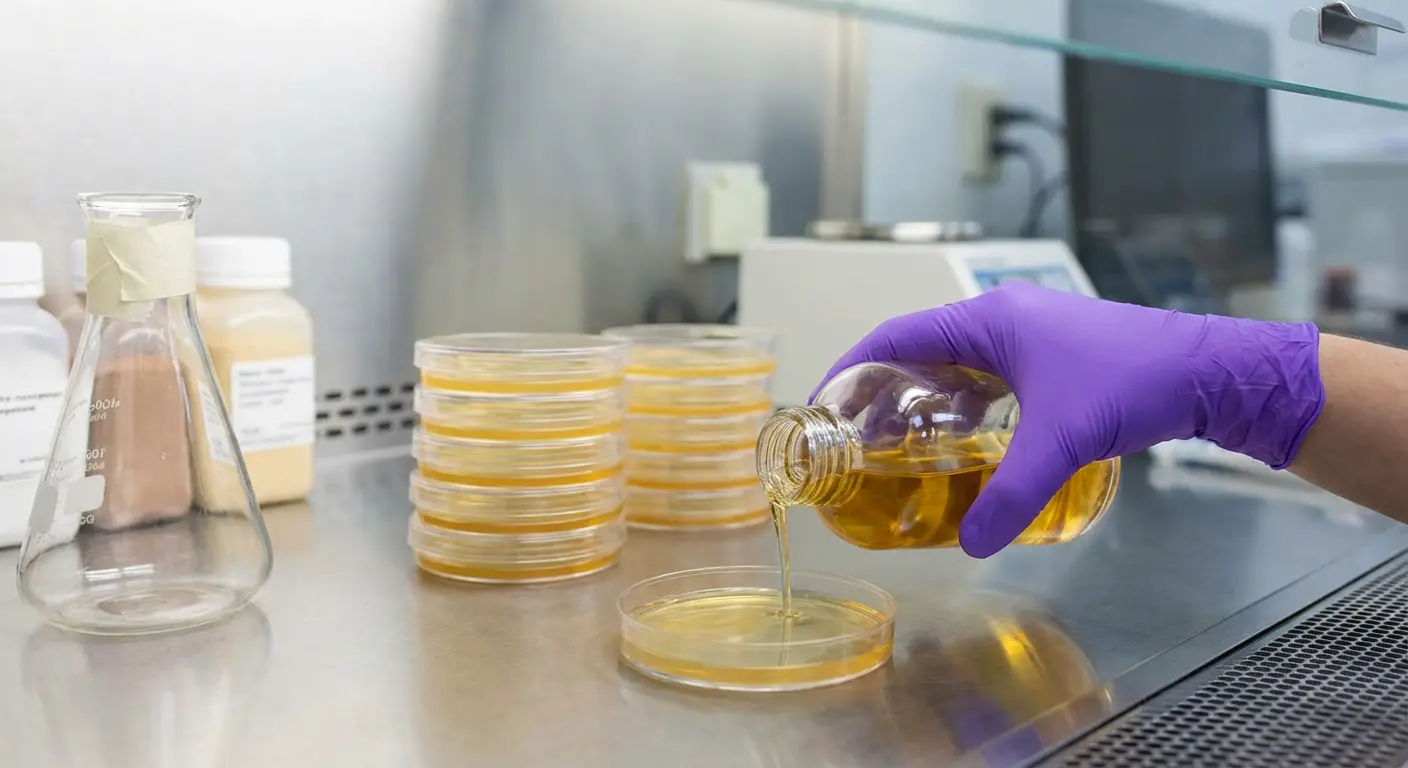

Préparation des Milieux de Culture : Une Étape Cruciale en Microbiologie
La préparation des milieux de culture est l'une des étapes les plus essentielles en microbiologie et biotechnologie. Ces milieux fournissent les nutriments nécessaires à la croissance des microorganismes en laboratoire, permettant ainsi aux chercheurs d'étudier divers aspects de la biologie microbienne, de la génétique à la résistance aux antibiotiques. Dans cet article, nous vous guiderons à travers l'importance de la préparation des milieux de culture, les différents types disponibles et les bonnes pratiques à suivre pour assurer des résultats fiables.
Un milieu de culture est une solution ou un gel qui fournit aux microorganismes les nutriments essentiels à leur croissance, leur reproduction et leur développement. Il contient des substances telles que des sels minéraux, des acides aminés, des sucres et parfois des vitamines ou des facteurs de croissance spécifiques. Ces milieux sont utilisés pour cultiver une variété de micro-organismes, y compris les bactéries, les levures, les champignons et même les cellules animales ou végétales en culture cellulaire.
Il existe plusieurs types de milieux de culture, chacun étant conçu pour des objectifs spécifiques :
Milieux de culture solides : Ces milieux contiennent un agent gélifiant (souvent de l'agar-agar), ce qui permet de créer des plaques solides utilisées pour isoler des colonies de microorganismes. Ils sont largement utilisés pour les cultures bactériennes et fongiques.
Milieux de culture liquides : Ces milieux ne contiennent pas de gélifiant et sont utilisés pour la culture de microorganismes en suspension. Ils sont particulièrement utiles pour les tests de croissance à grande échelle.
Milieux sélectifs : Ces milieux contiennent des agents chimiques qui favorisent la croissance de certains types de micro-organismes tout en inhibant la croissance d'autres. Par exemple, les milieux sélectifs sont souvent utilisés pour isoler des bactéries résistantes à des antibiotiques spécifiques.
Milieux différenciateurs : Ces milieux permettent de distinguer différents types de microorganismes sur la base de leurs caractéristiques de croissance, comme la couleur des colonies, la production d'acides ou la dégradation de certains composés.
La préparation des milieux de culture nécessite de suivre une méthode précise pour garantir que les milieux sont stériles et adaptés à la croissance des microorganismes visés. Voici un aperçu des principales étapes :
1. Choisir le bon milieu de culture
Il est essentiel de sélectionner un milieu qui correspond aux besoins nutritionnels du microorganisme que vous souhaitez cultiver. Par exemple, pour cultiver des bactéries pathogènes, un milieu riche en nutriments comme le milieu de culture Luria-Bertani (LB) est souvent utilisé.
2. Pesée des composants
Les composants du milieu sont pesés avec précision. Cela inclut les sels, les acides aminés, les sucres, et d’autres substances spécifiques à ajouter. Chaque ingrédient doit être dosé avec soin pour obtenir les concentrations correctes, ce qui est essentiel pour favoriser une croissance optimale.
3. Dissolution et ajustement du pH
Une fois que les ingrédients sont ajoutés, le mélange est dissous dans de l’eau distillée. Le pH du milieu est ensuite ajusté à la valeur optimale à l’aide de solutions acides ou basiques. Le pH est crucial car il influence la solubilité des nutriments et l'activité des enzymes microbiennes.
4. Stérilisation
La stérilisation des milieux de culture est une étape essentielle pour éviter la contamination par d’autres microorganismes. Cela peut être réalisé par autoclavage (chauffage sous pression) ou filtration stérile, selon le type de milieu.
5. Vérification de la stérilité et de la qualité
Après stérilisation, il est important de vérifier que le milieu de culture est exempt de contaminants. Cette étape inclut des tests de contrôle de la stérilité et l’observation de la clarté du milieu.
Bonnes pratiques et conseils
Travailler dans des conditions stériles : Il est impératif de préparer les milieux dans un environnement propre et stérile pour éviter toute contamination croisée. L’utilisation de laminoirs à flux laminaire et d’autoclaves est essentielle.
Vérifier les dates de péremption des composants : Utiliser des ingrédients frais garantit la qualité et la fiabilité du milieu de culture. Les milieux doivent être stockés à des températures appropriées pour préserver leur efficacité.
Suivre des protocoles validés : Les protocoles de préparation des milieux doivent être respectés à la lettre pour éviter toute erreur qui pourrait affecter les résultats des cultures. Il est conseillé de travailler avec des fiches techniques et des manuels de protocoles éprouvés.
Conclusion
La préparation des milieux de culture est un aspect fondamental de la microbiologie moderne. Un milieu bien préparé offre des conditions idéales pour la croissance des micro-organismes et permet d’obtenir des résultats fiables et reproductibles. En suivant les bonnes pratiques, vous pouvez vous assurer que vos expériences sont menées dans les meilleures conditions possibles. Que vous soyez en train d'étudier des pathogènes ou de mener des recherches génétiques, une préparation adéquate des milieux est essentielle pour atteindre vos objectifs scientifiques.